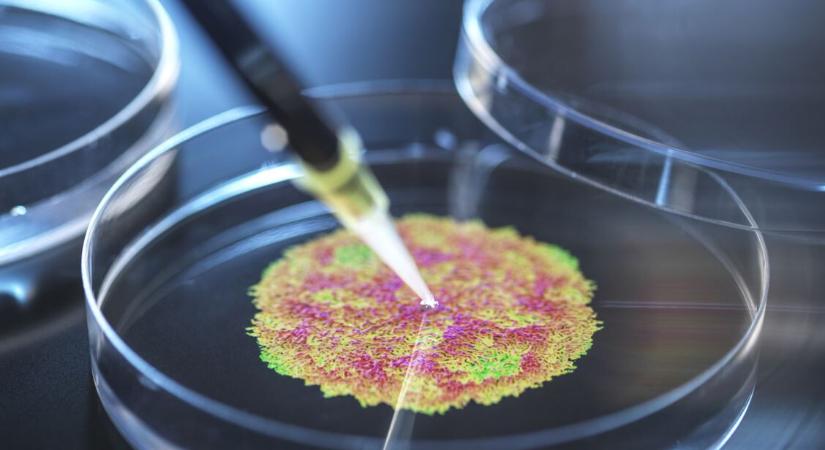
Aggasztó: újra megjelent Európában a vírus, amely a gyermekbénulást okozza

Aggasztó: újra megjelent Európában a vírus, amely a gyermekbénulást okozza
Harminc év után mutatták ki ismét a gyermekbénulás kórokozóját Németországban a szennyvízből vett mintákban.

Hamarosan átirányítunk a teljes cikkhez → HáziPatika
Harminc év után mutatták ki ismét a gyermekbénulás kórokozóját Németországban a szennyvízből vett mintákban.
Hamarosan átirányítunk a teljes cikkhez → HáziPatika